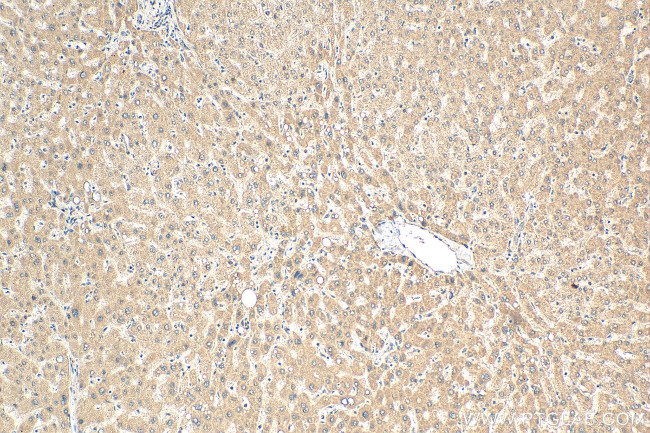
WDR7 Antibody in Immunohistochemistry (Paraffin) (IHC (P))
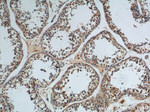
WDR7 Antibody in Immunohistochemistry (Paraffin) (IHC (P))

Search
Proteintech
WDR7 Polyclonal Antibody
{{$productOrderCtrl.translations['antibody.pdp.commerceCard.promotion.promotions']}}
{{$productOrderCtrl.translations['antibody.pdp.commerceCard.promotion.viewpromo']}}
{{$productOrderCtrl.translations['antibody.pdp.commerceCard.promotion.promocode']}}: {{promo.promoCode}} {{promo.promoTitle}} {{promo.promoDescription}}. {{$productOrderCtrl.translations['antibody.pdp.commerceCard.promotion.learnmore']}}
产品信息
24431-1-AP
种属反应
宿主/亚型
分类
类型
抗原
偶联物
形式
浓度
规格
纯化类型
保存液
内含物
保存条件
运输条件
产品详细信息
Immunogen sequence: LLTRPRSSS QIPEGFGLTS GGSNYSLARH TCKALTFLLL QPPSPKLPPH STIRRTAIDL IGRGFTVWEP YMDVSAVLMG LLELCADAEK QLANITMGLP LSPAADSARS ARHALSLIAT ARPPAFITTI AKEVHRHTAL AANTQSQQNM HTTTLARAKG EILRVIEILI EKMPTDVVDL LVEVMDIIMY CLEGSLVKKK GLQECFPAIC RFYMVSYYER NHRIAVGARH GSVALYDIRT GKCQTIHGHK GPITAVAFAP DGRYLATYSN TDSHISFWQM NTSLLGSIGM LNSAPQLRCI KTYQVPPVQP ASPGSHNALK LARLIWTSNR NVILMAHDGK EHRFMV (1145-1490 aa encoded by BC131558)
靶标信息
This gene encodes a member of the WD repeat protein family. WD repeats are minimally conserved regions of approximately 40 amino acids typically bracketed by gly-his and trp-asp (GH-WD) that may facilitate formation of heterotrimeric or multiprotein complexes. Members of this family are involved in a variety of cellular processes, including cell cycle progression, signal transduction, apoptosis, and gene regulation. The encoded protein forms the beta subunit of rabconnectin-3 and binds directly with Rab3A GDP/GTP exchange protein and indirectly with Rab3A GDP/GTP activating protein; these proteins are regulators of Rab3 small G protein family members involved in control of the calcium-dependent exocytosis of neurotransmitters. Alternatively spliced transcript variants encoding different isoforms have been described.
仅用于科研。不用于诊断过程。未经明确授权不得转售。
生物信息学
蛋白别名: Rabconnectin-3 beta; rabconnectin-3beta; TGF-beta resistance associated; TGF-beta resistance-associated protein TRAG; WD repeat-containing protein 7
基因别名: AI462727; KIAA0541; mKIAA0541; TRAG; Wd7; WDR7
UniProt ID: (Human) Q9Y4E6, (Mouse) Q920I9, (Rat) Q9ERH3
Entrez Gene ID: (Human) 23335, (Mouse) 104082, (Rat) 66031